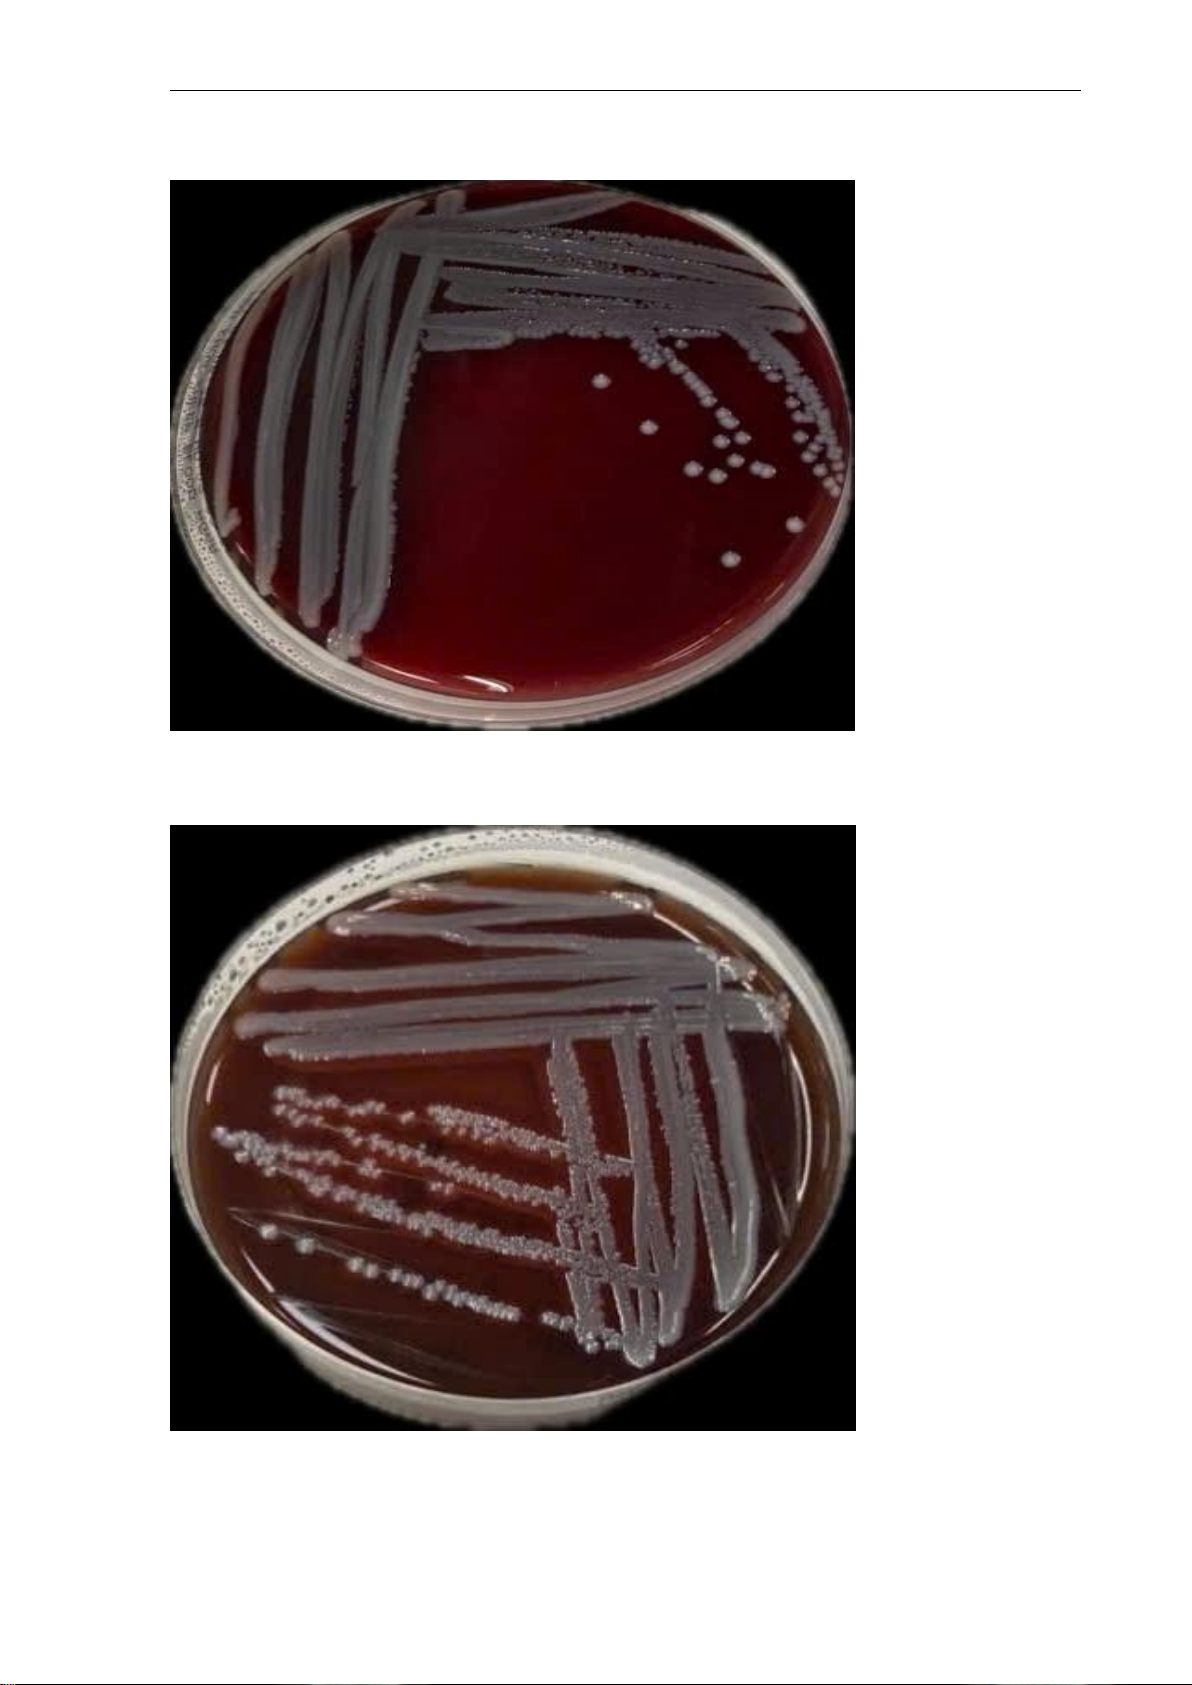

Preview text:
lOMoARcPSD| 60380256 BÁO CÁO THỰC HÀNH Vi sinh lâm sàng Lớp: 71K30RHMA01 Năm học: 2025
Họ và tên sinh viên: Phạm Hùng Vỹ MSSV: 2477205010109
THỰC HÀNH NUÔI CẤY, PHÂN LÂP VI KHUẨṆ Yêu cầu:
Thực hiện phân lâp vi khuẩn với mẫu được cung cấp ̣
a. Kể tên các môi trường phân lâp vi khuẩn ̣
- Môi trường MC (MacConkey Agar): có khả năng ức chế vi khuẩn Gram dương,
tạo điều kiện cho các vi khuẩn Gram âm dễ mọc phát triển, giúp phân biệt vi
khuẩn Coliform và vi khuẩn không lên men Lactose.
- Môi trường BA (Blood Agar): phát hiện hiện tượng tan huyết (alpha, beta,
gamma), tạo điều kiện phát triển cho vi khuẩn Gram dương.
- Môi trường MHA (Mueller Hinton Agar): Có các thành phần giàu dinh dưỡng
cần thiết cho sự phát triển của vi sinh vật.
- Môi trường Sheep Blood Agar (SBA) : được sử dụng để phân loại và định tính
vi khuẩn. SBA cho phép phát hiện và phân biệt các loại vi khuẩn dựa trên khả
năng của chúng tạo ra các tác động đặc biệt trên máu. Cụ thể, một số vi khuẩn
có khả năng phân huỷ hồng cầu trong máu, gây ra hiện tượng hiện màu xanh
xám hoặc mờ xung quanh các đơn vị khuẩn trên môi trường agar.
b. Mô tả kỹ thuật cấy ria tạo khuẩn lạc đơn.
- Khử trùng que cấy vòng bằng đèn cồn → làm nguội.
- Lấy mẫu vi khuẩn từ môi trường tăng sinh hoặc bệnh phẩm.
- Cấy mẫu ở góc đầu tiên của đĩa → thực hiện ria theo kiểu chữ T hoặc zích-zắc
qua nhiều vùng thạch. ( Có thể cấy 3 vùng: dùng que cấy ria lên mặt thạch và
xoay mặt thạch với các góc 120o hoặc cấy 4 vùng ).
- Sau mỗi vùng ria, khử trùng và làm nguội que cấy lại trước khi tiếp tục.
- Đặt đĩa vào tủ ấm 37°C, sau đó theo dõi sự phát triển của vi khuẩn trong vòng 18–24 giờ. lOMoARcPSD| 60380256
c. Hình ảnh cấy ria 01 và 02 trên các môi trường phân lâp̣ Hình ảnh cấy ria 01 Hình ảnh cấy ria 02 lOMoARcPSD| 60380256 BÁO CÁO THỰC HÀNH Vi sinh lâm sàng Lớp: 71K30RHMA01 Năm học: 2025
Họ và tên sinh viên: Phạm Hùng Vỹ MSSV: 2477205010109
THỰC HÀNH NHUỘM GRAM, KHÁNG ACID
1. Nhuộm Gram chủng VSV cho sẵn
- Ghi vắn tắt cách sử dụng kính hiển vi, cách chỉnh để thấy rõ mẫu VSV ở vật kính 40x và 100x
Vật kính 40x: Sau khi quan sát rõ ở 10x, xoay tháp kính để chuyển
sang vật kính 40x. Điều chỉnh ốc vĩ cấp để lấy nét sơ bộ, điều chỉnh
ốc vi cấp để điều chỉnh hình ảnh rõ nét.
Vật kính 100x: Vật kính 100x thường sử dụng dầu soi nổi. Đặt một
giọt dầu lên tiêu bản, xoay tháp kính để vật kính 100x tiếp xúc với
dầu. Nhìn vào thị kính và điều chỉnh ốc vĩ cấp để lấy nét sơ bộ, điều
chỉnh ốc vi cấp để điều chỉnh hình ảnh rõ nét.
- Giải thích sự khác nhau của thành tế bào vi khuẩn Gram âm và
Gram dương đáp ứng trong việc nhuộm phân biệt hai nhóm vi khuẩn
này? Các nguyên nhân sai lệch có thể có khi nhuộm Gram. Hình ảnh
nhuộm Gram (có chú thích trên ảnh). * Sự khác nhau: Vi khuẩn Gram dương Vi khuẩn Gram âm -
Độ dày của thành tế bào khoảng 510 nm. -
Độ dày của thành tế bào - Lớp Peptidoglycan mỏng. khoảng 2080 nm. -
Thành tế bào dạng gợn sóng. - Lớp Peptidoglycan dày. - Thành tế bào nhẵn.
* Các nguyên nhân sai lệch có thể có khi nhuộm Gram: - Gram (+) thành Gram (-): + Lứa cấy qúa già
+ Dung dịch Lugol bị hỏng + Tẩy màu quá mức - Gram (-) thành Gram (+) lOMoARcPSD| 60380256
+ Cố định tiêu bản khi còn ướt + Tẩy màu chưa đạt
* Hình ảnh nhuộm Gram (có chú thích trên ảnh):
- String test dựa trên nguyên lý nào? Các hạn chế có thể xảy * Nguyên lý:
+ Giống như nhuộm Gram, KOH test dựa trên sự khác nhau về
mặt hoá học của thành tế bào vi khuẩn. Khi có mặt KOH, tế bào vi khuẩn
Gram (-) sẽ bị phá vỡ, giải phóng các chất nội bào, kể cả các thành phần
của NST làm cho hỗn dịch tế bào có tính đặc và có tính nhớt.
+ Trong khi đó , vi khuẩn Gram (+) không bị ảnh hưởng nhiều bởi
KOH vì có lớp Peptidoglycan dày, tế bào không bị vỡ, không có DNA
phóng thích ra ngoài, → không có độ nhớt.
* Hạn chế của phương pháp:
+ Mẫu cấy lâu (> 48h) có thể cho kết quả dương sau 30s, thường
gặp ở các nhóm Achromobacter, Bruceela melitensis, Pseudomonas
paucimobilis, Moraxella... lOMoARcPSD| 60380256
+ Dương tính giả có thể xảy ra khi quá nhiều vi khuẩn (có thể
đặc nhưng không tạo dạng gel) hay nhóm vi khuẩn có khuẩn lạc nhầy.
+ Âm tính giả khi quá ít vi khuẩn hay quá nhiều KOH .
2. Quan sát lam kính nhuôm kháng acid:̣
- Vì sao phải sử dụng phương pháp nhuộm kháng acid cho nhóm VSV này?
- Thành tế bào chứa acid mycolic:
+ Vi khuẩn kháng acid có lớp vỏ sáp dày, giàu acid mycolic và lipid
+ Lớp này ngăn cản thuốc nhuộm thấm vào và giữ màu sau khi tẩy bằng acid - cồn
- Không bắt màu Gram:
+ Do cấu trúc vách tế bào đặc biệt, các vi khuẩn này không giữ được
màu tím gentian trong nhuộm Gram
+ Nếu dùng Gram, sẽ cho kết quả âm tính giả hoặc không rõ hình
ảnh - Khả năng kháng tẩy mạnh:
+ Sau khi nhuộm bằng carbol fuchsin, vi khuẩn kháng acid vẫn giữ
màu đỏ dù bị tẩy bằng acid - cồn
+ Các vi khuẩn khác sẽ mất màu → tạo nền xanh khi nhuộm tương phản bằng methylene blue
- Mô tả cách sắp xếp và hình dạng vi khuẩn trên lame kính của
mẫu nhuôm kháng aciḍ Màu sắc
Hình dạng vi khuẩn Cách sắp xếp Hồng Hình que
Rải rác, đơn lẻ hoặc nhóm nhỏ a.
Đọc kết quả của mẫu nhuôṃ
kháng acid
AFB/100 quang trường AFB/1 quang trường Kết quả (+++) (toàn bộ lam kính) b.
Chụp hình nhuôm ̣ kháng acid lOMoARcPSD| 60380256 lOMoARcPSD| 60380256
BÁO CÁO THỰC HÀNH Vi sinh lâm sàng Lớp: 71K30RHMA01 Năm học: 2025
Họ và tên sinh viên: Phạm Hùng Vỹ MSSV: 2477205010109
THỰC HÀNH ĐỊNH DANH VI KHUẨN Yêu cầu:
Thực hiện định danh vi khuẩn a.
Kết quả định danh bằng thử nghiêm sinh ḥ óa : + Catalase (-)/(+): + Coagulase (-)/(+): b.
Hình ảnh thử nghiêm catalase ṿ à coagulase a.
Kết quả định danh bằng kit – Mã số mẫu:
Hình ảnh kit định danh và kết quả đọc kit. lOMoARcPSD| 60380256 b. Kết luận:
- Chủng vi khuẩn 01 là vi khuẩn:
- Chủng vi khuẩn 02 là vi khuẩn: lOMoARcPSD| 60380256 BÁO CÁO THỰC HÀNH Vi sinh lâm sàng Lớp: 71K30RHMA01 Năm học: 2025
Họ và tên sinh viên: Phạm Hùng Vỹ MSSV: 2477205010109
THỰC HÀNH KỸ THUẬT KHÁNG SINH ĐỒ -
PHƯƠNG PHÁP ĐĨA GIẤY Yêu cầu:
Thực hiện kỹ thuật kháng sinh đồ đĩa giấy trên mẫu vi khuẩn được cung
cấp- Mã số mẫu: a.
Mô tả ngắn gọn quy trình kỹ thuật kháng sinh đồ đĩa giấy:
- Chuẩn bị huyền dịch vi khuẩn: Pha huyền dịch vi khuẩn 108
VK/ml ( so với độ đục chuẩn 0,5 Mc Farland) + Trải vi khuẩn lên mặt thạch:
+ Dùng tăm bông vô khuẩn nhúng vào huyền dịch
+ Ria đều lên bề mặt thạch Mueller–Hinton Agar (MHA) - Đặt đĩa kháng sinh +
Chọn các khoanh giấy tẩm kháng sinh phù hợp +
Đặt nhẹ lên mặt thạch, cách đều nhau và cách mép đĩa từ 2
– 2,5cm và khoảng cách các đĩa kháng sinh từ 2,5 – 3,5cm.
- Ủ đĩa thạch: Lật úp đĩa và ủ ở 37°C trong 18 - 24 giờ - Đọc kết quả
+ Đo đường kính vùng ức chế quanh khoanh giấy (mm) +
So sánh với bảng chuẩn CLSI để phân loại:
S (nhạy), I (trung gian), R (kháng) b.
Trình bày điều kiện nuôi ủ sau khi đặt đĩa kháng sinh: ủ ở 37°C
trong 18 - 24 giờ. Lưu ý: Không nên ủ trong khí trường CO₂ nếu không
được khuyến cáo, vì có thể ảnh hưởng đến đường kính vùng ức chế c.
Điền kết quả kháng sinh đồ vào bảng: Tên vi khuẩn: Mẫu C01:
Vòng vô khuẩn tiêu Đường Kháng sinh chuẩn (mm) kính vòng Kết quả Ghi chú Nồng độ (µg) vô khuẩn Trung (R,I,S) Kháng Nhạy (mm) gian Ampicillin (30) 13 13-17 17 lOMoARcPSD| 60380256 Gentamicin (10) 13 13-14 14 Trimethroprim/ 10 13-16 16 Sulfamethoxazole (1,25/23,75) Piperacillin (100) 18 Ciprofloxacin (5) 21 21-26 26 Ertapenem (10) 18 18-22 22 Cefepime (30) 15 15-17 17 Cefotaxime (30) 22 22-26 26 Amoxilin/Clavulanic 13 14-17 17 acid (20/10) Ceftazidime (30) 15 15-17 17 Amikacin (30) 14 14-17 17
R:Resistance (Kháng) I: Intermediate (Trung gian) S: Sensitive ( Nhạy) d.
Những điểm cần lưu ý khi đọc kết quả:
Các thao tác dàn bệnh phẩm và đặt kháng sinh không chuẩn dẫn đến sai lệch kết quả.
Nhiệt độ ủ ấm và thời gian quá dài khiến cho vi khuẩn được nhân lên nhiều,
làm giảm đường kính vùng ức chế, kết quả nhạy cảm có thể bị đọc nhầm thành kết quả đề kháng.
Vi khuẩn được cấy lên thạch quá dày hoặc quá thưa.
Đo đường kính vòng vô khuẩn sai.
Bị lẫn các vi khuẩn khác.
So sánh với chuẩn R/I/S để phân tích độ nhạy. e.
Hình ảnh kháng sinh đồ phương pháp đĩa giấy
BÁO CÁO THỰC HÀNH Vi sinh lâm sàng Lớp: 71K30RHMA01 Năm học: 2025
Họ và tên sinh viên: Phạm Hùng Vỹ MSSV: 2477205010109 lOMoARcPSD| 60380256
THỰC HÀNH KỸ THUẬT KHÁNG SINH ĐỒ - PHƯƠNG PHÁP E-TEST Yêu cầu:
Thực hiện kỹ thuật kháng sinh đồ phương pháp E-test trên mẫu vi
khuẩn được cung cấp – Mã số mẫu: C02 a.
Mô tả cách đặt que E-test trên đĩa môi trường đã trải vi khuẩn
Dùng kẹp đã khử trùng bằng cách hơ trên lửa đèn cồn và để nguội để đặt
que E-test lên mặt thạch (que E-test phải tiếp xúc phẳng trên bề mặt thạch,
mặt có số hướng lên trên), không được di chuyển que sau khi đã đặt lên thạch b.
Trình bày môi trường và các điều kiện nuôi ủ khi làm kháng sinh đồ vi khuẩn c.
Kết quả kháng sinh đồ Tên vi khuẩn: MIC Kháng sinh Kết quả tiêu chuẩn Ghi chú Nồng độ (µg) ( µg/mL) ( µg/mL) Vancomycine 32 4 - 8 2 d.
Những lưu ý khi đọc kết quả: e.
Hình ảnh kháng sinh đồ E-test lOMoARcPSD| 60380256